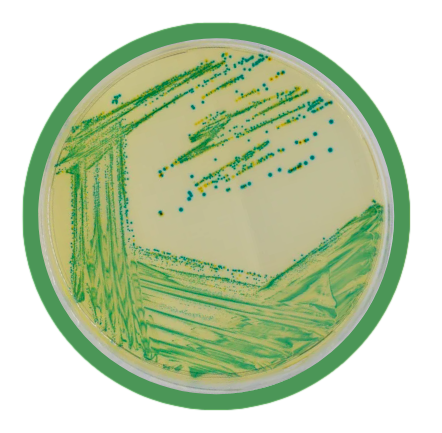
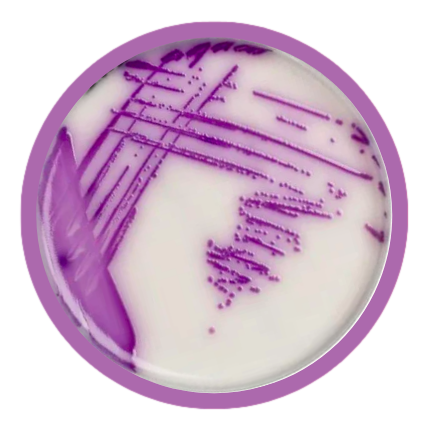
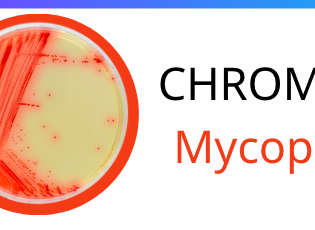

TIN TỨC
HardyCHROM™ a complete offering of Chromogenic Media
Classified as an urgent threat by the Centers for Disease Control and Prevention (CDC), Candida auris has caused much global concern. It is resistant to most first-line antifungal medications and spreads easily through direct contact as well as contact with contaminated surfaces. C. auris is predominant in patients with underlying medical issues or weakened immune systems.